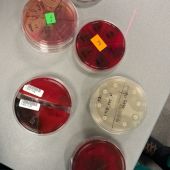

Wysłane przez moderator2 w pon., 12/08/2025 - 12:03
W czwartek 20 listopada uczennice klasy czwartej zwiedziły Weterynaryjne Laboratorium Analityczne Vetlab we Wrocławiu.
Celem wycieczki było zapoznanie uczennic z pracą laboratorium.Obejrzały pracownię badań krwi, moczu, kału, badań mikrobiologicznych i serologicznych.Samodzielnie mogły wykonać posiewy, obsłużyć profesjonalne analizatory i preparaty pod mikroskopem. Uczennice przekonały się o tym, jak ważna jest odpowiedzialność precyzja w pracy laboratoryjnej w zawodzie analityka laboratoryjnego.
Wycieczkę zorganizowały nauczycielki zawodu.